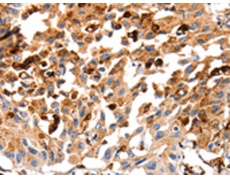
一抗

|
Background: |
The protein encoded by this gene is a lysosomal cysteine proteinase composed of a dimer of disulfide-linked heavy and light chains, both produced from a single protein precursor. It is also known as amyloid precursor protein secretase and is involved in the proteolytic processing of amyloid precursor protein (APP). Incomplete proteolytic processing of APP has been suggested to be a causative factor in Alzheimer disease, the most common cause of dementia. Overexpression of the encoded protein, which is a member of the peptidase C1 family, has been associated with esophageal adenocarcinoma and other tumors. At least five transcript variants encoding the same protein have been found for this gene. |
|
Applications: |
ELISA, IHC |
|
Name of antibody: |
CTSB |
|
Immunogen: |
Fusion protein of human CTSB |
|
Full name: |
cathepsin B |
|
Synonyms: |
APPS, CPSB |
|
SwissProt: |
P07858 |
|
ELISA Recommended dilution: |
1000-5000 |
|
IHC positive control: |
Human lung cancer |
|
IHC Recommend dilution: |
50-100 |

 購物車
購物車 幫助
幫助
 021-54845833/15800441009
021-54845833/15800441009